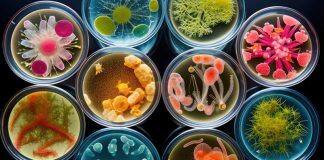
$2m funding boost for innovative health and medical projects

About Australia Education News, Study in Australia, Education in Australia, Australia University, University News, University Ranking, Study Abroad, Online Education, Education News, Graduate Program, Undergraduate Programs, Admissions, etc…
Tag: Australia Education News
Women from diverse backgrounds still face leadership barriers: study
Australian leaders with diverse backgrounds have expressed a sense of resignation and despair about the lack of women from First Nations and Culturally and Linguistically Diverse (CALD) backgrounds in leadership roles.
Young women can ‘bank’ exercise for better heart health
Researchers from The University of Queensland have found women can retain the benefits of exercise during their 20s, going on to have better heart health later in life.
$2m funding boost for innovative health and medical projects
Four researchers at The University of Western Australia have received nearly $2 million funding for projects including developing new therapy for liver cancer and pursuing a new treatment for gonorrhoea.
How to apply for studying abroad in Australia?
With its world-class universities, multicultural society, beautiful natural landscapes, and friendly people, Australia has become one of the most popular destinations for international students.
Evolution wired human brains to act like supercomputers
Scientists have confirmed that human brains are naturally wired to perform advanced calculations, much like a high-powered computer, to make sense of the world through a process known as Bayesian inference.
Why new mothers are more likely to see faces in everyday...
A University of Queensland study has found women who’ve just had a baby are much more likely to see faces in everyday objects than other women.
Renewable backup power key to energy resilience in disasters: report
Households need more support to implement alternative energy solutions to help manage outages during bushfires and extreme weather events.
High water mark for innovative UQ flood monitoring system
A tool developed by researchers at The University of Queensland that measures floodwater depth and velocity will be sold globally after it was licensed to a US-based company.
Climate change is reducing global river water quality
A review of almost 1000 studies on the effects of climate change and extreme weather events on rivers around the world has found an overall negative effect on water quality in rivers globally.
World-first fusion device to be built at UNSW Sydney
A small-scale tokamak device – designed, built and managed by UNSW students – is set be housed at university’s main Kensington campus.